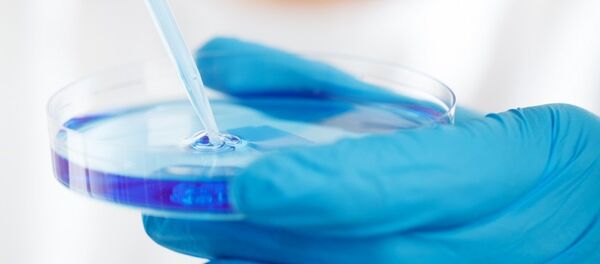
Лаборатория Лаборатория - Sputnik Абхазия

Документ, призывающий к "мозговому штурму", опубликовало на сайте оборонных госзакупок Управление перспективных исследовательских проектов Министерства обороны США (DARPA) — кузница американского военного хайтека. В тексте прямо признается: сегодня Пентагон не располагает технологиями для победы над равным по силе противником на его территории. Как DARPA собирается это исправить — в материале РИА Новости.
Навигация и связь
В документе подчеркивается: вооруженные силы США заинтересованы в прорывных технологиях, позволяющих доминировать в конфликтах различной интенсивности и эффективно сражаться как в общевойсковом бою с развитой армией, так и с иррегулярными вооруженными формированиями при отсутствии выраженной линии фронта. По мнению специалистов агентства, опыта, полученного армией США в иракской и афганской кампаниях, явно недостаточно для победы над соперником, "превосходящим США по численности сухопутных войск или парка боевой техники". Государств, которые соответствуют этому критерию и рассматриваются Пентагоном в качестве вероятного противника, не так уж много — КНДР, Китай, Иран и Россия.
DARPA констатирует: ахиллесова пята вооруженных сил США — отсутствие надежных технологий для ведения боевых действий в мегаполисах с плотной высотной застройкой и развитой подземной инфраструктурой. Система глобального позиционирования GPS, без которой сегодня немыслима ни одна крупная операция Пентагона, работает не везде. То же самое касается и военных средств радиосвязи, возможности которой в густонаселенных районах серьезно ограничены высотками. А, скажем, метрополитен придется отвоевывать у противника практически вслепую — связь под землей работает гораздо хуже, чем на поверхности, спутниковая навигация и вовсе недоступна.
"Успех военной операции зависит от надежной и безопасной связи и глобального позиционирования на всех уровнях — от расположенных на территории США командных пунктов вплоть до бойца на передовой в другой части мира, — отмечается в конкурсной документации. — Наша цель — научиться максимально быстро и надежно предоставлять военнослужащим точную информацию, где бы они ни находились, и одновременно лишить этой возможности противника. Нужны новые системные концепции и технологии, которые улучшат доступность связи, ее охват и устойчивость к природным и рукотворным помехам. Приветствуются решения, основанные на существующих гражданских коммерческих технологиях и инфраструктуре".
Речь, вероятно, идет об использовании городской гражданской инфраструктуры связи и навигации противника на его территории в интересах американских военных — например, вышек сотовой связи и местных систем глобального позиционирования. В DARPA особо подчеркивают: для ведения боевых действий в крупных городах на чужой территории Пентагону необходимы технологии, не привязанные к GPS, устойчивые к воздействию средств радиоэлектронной борьбы и радиоэлектронного подавления.
Разведка и наблюдение
Отдельно прописана необходимость внедрения в войска технологий, упрощающих понимание оперативной обстановки американскими военнослужащими: "Преимущество в конфликтах будущего зависит от способностей наших специалистов быстро находить ответы на вопросы "кто, что, где, когда и почему", чтобы без задержек получать информацию о цели: ее типе, вооружении, местонахождении и скорости передвижения. Это крайне важно в городских условиях, где противник может смешаться с мирным населением. В Афганистане и Ираке США собирали большие объемы разведданных и анализировали их в центрах командования и контроля (Command and Control centers). Сегодня нужны новые технологии автоматизированного сбора и обработки информации".
DARPA заинтересована в оригинальных технологиях автоматического распознавания целей и новых алгоритмах обработки информации, чтобы, например, вычислить в толпе мирных жителей вооруженных военнослужащих противника, быстро обнаружить в плотном потоке машин армейский внедорожник, раскрыть замаскированную огневую точку в жилом здании. Технические средства для решения этих задач должны быстро развертываться небольшими подразделениями американских военнослужащих и иметь возможность использовать в интересах США элементы местной инфраструктуры — например, анализировать записи с камер видеонаблюдения, которые повсеместно установлены в мегаполисах.
Вновь подчеркивается необходимость адаптации гражданских технологий для нужд армии, чтобы "создать дешевые средства наблюдения, которые легко приспособить к различным условиям". Речь, вероятно, идет о массовом использовании для разведки и мониторинга окружающей обстановки коммерческих беспилотных летательных аппаратов. Недорогие дроны, которые легко приобрести через интернет или в магазине электроники, давно и активно применяются противоборствующими сторонами в Донбассе для наблюдения за противником и корректировки артиллерийского огня. Множество таких БПЛА, завязанных в единую сеть, позволит без особых затрат держать под наблюдением целые городские районы. А в некоторых случаях — наносить массированные удары по военным целям.
Американцы уже вовсю тестируют эту технологию в боевых условиях. В четверг замминистра обороны России Александр Фомин сообщил: январская атака боевиков ИГ* на российскую авиабазу Хмеймим в Сирии контролировалась военнослужащими США. Тогда, напомним, 13 кустарных беспилотников, загруженных взрывчаткой, попытались прорваться к стоянке бомбардировщиков, но были сбиты средствами ПВО. По словам Фомина, дронами управляли с американского самолета-разведчика "Посейдон", кружившего неподалеку.
Система систем
Большое внимание в документе DARPA уделено так называемой "системе систем" (System of systems) — глобальной высокоскоростной сети, объединяющей на поле боя всех военнослужащих США и их союзников, боевую технику, авиацию, беспилотные дроны, спутники и другие средства разведки и поражения. Оператор этой суперсети способен мгновенно менять конфигурацию атакующих сил, быстро распределять направления для наступления по городским улицам. Рядовой пехотинец в любой момент получает доступ к информации с БПЛА, а ударные дроны самостоятельно распределяют цели между собой.
DARPA подчеркивает: благодаря централизованному управлению силами и средствами, включая многочисленные легкие дроны различного назначения, сравнительно небольшие отряды (до 200 человек со штатным вооружением и ограниченной поддержкой с тыла) смогут успешно сражаться с многократно превосходящими силами противника. В документе они обозначены, как SoS-ESU — System of Systems — Enhanced small units ("Система систем — усиленные небольшие подразделения").
"DARPA заинтересовано в технологиях интеграции военнослужащих и беспилотных платформ на поле боя. Необходимо создать инновационный интерфейс, позволяющий операторам дронов одновременно управлять беспилотниками, нести оружие и вести активные боевые действия. SOS-ESU должны иметь возможность самостоятельно наносить удары по системам кибербезопасности противника, вызывать огневую поддержку, вести радиоэлектронную борьбу. "Система систем" должна легко настраиваться, чтобы к единой сети можно было быстро подключать союзников — от подразделений вооруженных сил стран — партнеров по коалиции до иррегулярных формирований. Нужно упростить координацию их действий без оглядки на культурные и языковые различия".
В целом направления для "мозгового штурма", выбранные DARPA, говорят о том, что в войнах будущего американцы делают ставку на небольшие подразделения, вооруженные по последнему слову техники и действующие при активной поддержке многочисленных легких дронов — от разведывательных до ударных. Смогут ли такие отряды успешно воевать в мегаполисе, где каждый дом — огрызающаяся огнем крепость, а техническое превосходство наступающего часто не имеет значения — вопрос открытый.
*Террористическая организация, запрещенная в России.